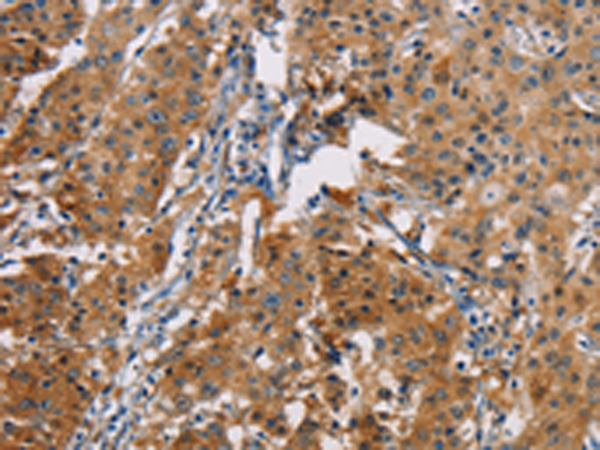
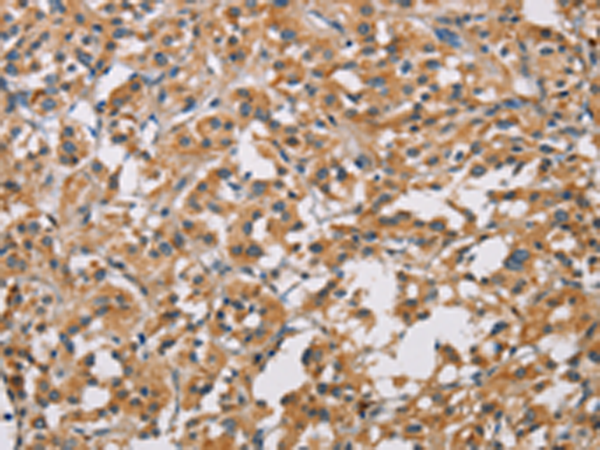
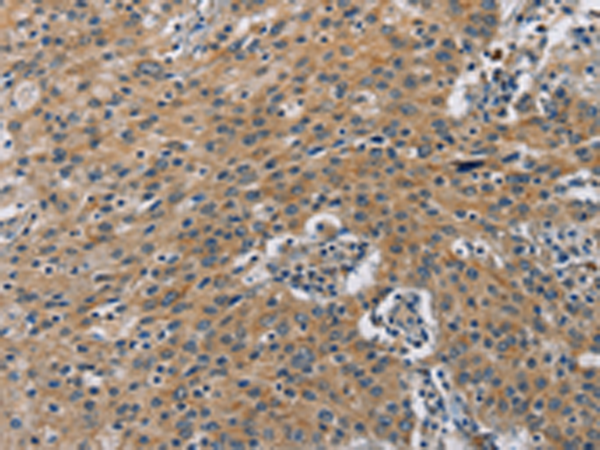
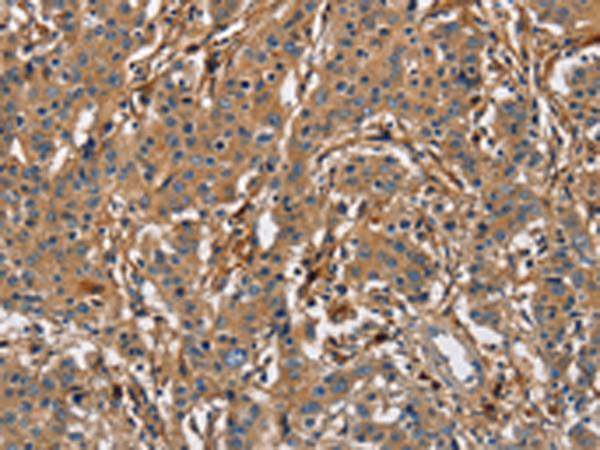

-
分类: 科研抗体货号: P08078别名: rBPI; BPIFD1应用: IHC反应种属: Human
-
分类: 科研抗体货号: P08060别名: B7DC; Btdc; PDL2; CD273; PD-L2; PDCD1L2; bA574F11.2应用: IHC反应种属: Human
-
分类: 科研抗体货号: P08077别名: ODG2; POF4; GDF9B应用: WB,IHC反应种属: Human
-
分类: 科研抗体货号: P08089别名: CAB1; CCHLB1; CACNLB1应用: IHC反应种属: Human, Mouse, Rat
-
分类: 科研抗体货号: P08075别名: ECE3; CD238应用: IHC反应种属: Human
-
分类: 科研抗体货号: P08088别名: CABL1; IK3-1; CABLES; HsT2563应用: WB,IHC反应种属: Human, Mouse
-
分类: 科研抗体货号: P08074别名: MODY11应用: WB,IHC反应种属: Human, Mouse
-
分类: 科研抗体货号: P08085别名: BUB1A; BUB1L; hBUB1应用: IHC反应种属: Human
-
分类: 科研抗体货号: P08104别名: NDPP; DACAR; DAKAR; NDPP1; TUCAN; CARDINAL应用: IHC反应种属: Human
-
分类: 科研抗体货号: P08084别名: BTF2; BT2.2应用: IHC反应种属: Human

鄂公网安备42018502007531号
鄂公网安备42018502007531号

